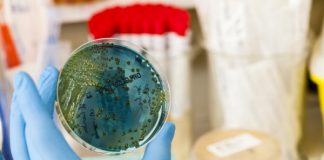

IT News
삼성전자, 역대 최고 속도 ‘12Gb LPDDR5’ 양산
삼성전자가 역대 최고 속도를 구현한 ‘12Gb(기가비트) LPDDR5(Low Power Double Data..
KEY MESSAGE
미드저니 훈련에 아티스트 1만6천명 리스트 존재
이미지 생성 AI 미드저니(Midjourney)의 학습에 사용된 것으로 추정되는..
AI가 10초 음성으로 당뇨병 진단…”정확도 86% 이상”
스마트폰에 녹음된 10초 정도의 목소리만으로 제2형 당뇨병 여부를..
“코로나 후유증 세로토닌 고갈과 관련 있다”
신종 코로나바이러스 감염증 후유증 '롱 코로나'(Long COVID)가 세로토닌..
소행성 ‘베누’에 생명체 위한 물·탄소 존재
미국 항공우주국(NASA) 탐사선이 회수한 소행성 ‘베누(Bennu)’ 샘플에서 생명체에..
“집 없으면 흡연, 비만보다 빨리 늙는다”
임대주택 거주자가 자가 소유자보다 생물학적 노화가 더 빠르다는..
























![[보고서] 딥씨크 출현과 한국 AI 미래전략](http://ww.itnews.or.kr/wp-content/uploads/2025/02/7-218x150.png)

![[2024 애플 동향] ③ 애플카 ‘프로젝트 타이탄’의 실패 원인](http://ww.itnews.or.kr/wp-content/uploads/2024/03/1-2-218x150.png)
![[2024 애플 동향] ② 애플카 ‘프로젝트 타이탄’ 10년간 의 여정](http://ww.itnews.or.kr/wp-content/uploads/2024/03/4-218x150.png)
![[2024 애플 동향] ① 애플 프로젝트 타이탄’ 종료](http://ww.itnews.or.kr/wp-content/uploads/2024/03/Midjourney-218x150.png)
![[스타트업] 살린, 소셜 미디어 플랫폼으로 태국 진출](http://ww.itnews.or.kr/wp-content/uploads/2019/11/3554238800_20190718095807_2442268098-324x160.jpg)